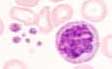

Es besteht eine normochrome, normozytäre Anämie mit Anisozytose, Poikilozytose und tränenförmigen Erythrozyten sowie ein leukoerythroblastäres Blutbild mit Normoblasten und myeloischen Vorstufen. Megekaryozytenkernresten sind oft vorhanden.
Es besteht eine normochrome, normozytäre Anämie mit Anisozytose, Poikilozytose und tränenförmigen Erythrozyten sowie ein leukoerythroblastäres Blutbild mit Normoblasten und myeloischen Vorstufen. Megekaryozytenkernresten sind oft vorhanden.Kurzbeschreibung:
Die Osteomyelofibrose gehört zu den myeloproliferativen Syndromen und ist charakterisiert durch eine Fibrosierung des Knochenmarks. Daraus resultiert eine zunehmende Knochenmarkinsuffizienz, die durch das Auftreten einer extramedullären Blutbildung kompensiert wird. Die klonale Störung ist in den Megakaryozyten lokalisiert. Diese sind vermehrt und produzieren Zytokine und Wachstumshormone (u.a. platelet derived growth factor=PDGF, platelet factor 4), welche die Proliferation von Fibroblasten anregen.
Klinisches Bild:
Die Patienten sind meist über 50. Die Krankheit beginnt schleichend mit Müdigkeit und Gewichtsverlust. Eine Splenomegalie ist obligat und kann durch ihre enorme Grösse zu Abdominalbeschwerden führen. Die meisten Patienten haben zudem eine Hepatomegalie. Im Röntgen kann man unter Umständen eine Sklerosierung der Knochen beobachten.
Hämatologie:
Es besteht eine normochrome, normozytäre Anämie mit Anisozytose, Poikilozytose und tränenförmigen Erythrozyten sowie ein leukoerythroblastäres Blutbild mit Normoblasten und myeloischen Vorstufen. Megekaryozytenkernresten sind oft vorhanden.
Es besteht eine normochrome, normozytäre Anämie mit Anisozytose, Poikilozytose und tränenförmigen Erythrozyten sowie ein leukoerythroblastäres Blutbild mit Normoblasten und myeloischen Vorstufen. Megekaryozytenkernresten sind oft vorhanden.
Knochenmark
 Die Knochenmarkaspiration ergibt kein Material (Punctio sicca), weshalb eine Knochenmarkbiopsie notwendig ist. Diese zeigt eine Zunahme der Megakaryozyten sowie eine Fibrosierung. Mittels Silberimprägnation (Gömöri-Färbung) lässt sich die Zunahme der Retikulinfasern (grüne Pfeile) nachweisen.
Die Knochenmarkaspiration ergibt kein Material (Punctio sicca), weshalb eine Knochenmarkbiopsie notwendig ist. Diese zeigt eine Zunahme der Megakaryozyten sowie eine Fibrosierung. Mittels Silberimprägnation (Gömöri-Färbung) lässt sich die Zunahme der Retikulinfasern (grüne Pfeile) nachweisen.